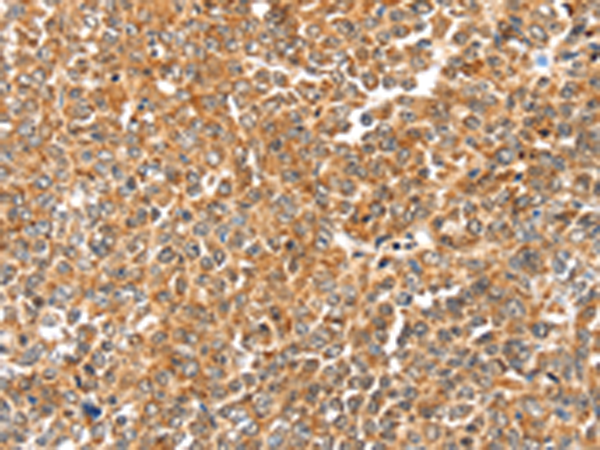

-
分类: 科研抗体货号: P05037别名:应用: WB,IHC反应种属: Human
-
分类: 科研抗体货号: P04994别名: hbeta1; BKbeta1; SLO-BETA; hslo-beta; K(VCA)beta; slo-beta-1; k(VCA)beta-1应用: WB反应种属: Human, Mouse
-
分类: 科研抗体货号: P05121别名:应用: WB,IHC反应种属: Human
-
分类: 科研抗体货号: P05035别名: HCA1; DAMAGE应用: WB,IHC反应种属: Human
-
分类: 科研抗体货号: P05098别名: BAFFR; CD268; CVID4; BAFF-R; BROMIX; prolixin应用: WB,IHC反应种属: Human, Mouse
-
分类: 科研抗体货号: P05119别名: OMGP应用: WB,IHC反应种属: Human, Mouse
-
分类: 科研抗体货号: P05034别名: CT7; CT7.1应用: IHC反应种属: Human
-
分类: 科研抗体货号: P05079别名: RNO; PAN6; RNO2; FCAS2; NALP12; PYPAF7; CLR19.3应用: IHC反应种属: Human, Mouse
-
分类: 科研抗体货号: P05118别名: 2-Oct应用: WB,IHC反应种属: Human, Rat
-
分类: 科研抗体货号: P05023别名: LOR2; WS9-14应用: IHC反应种属: Human, Mouse, Rat

鄂公网安备42018502007531号
鄂公网安备42018502007531号

